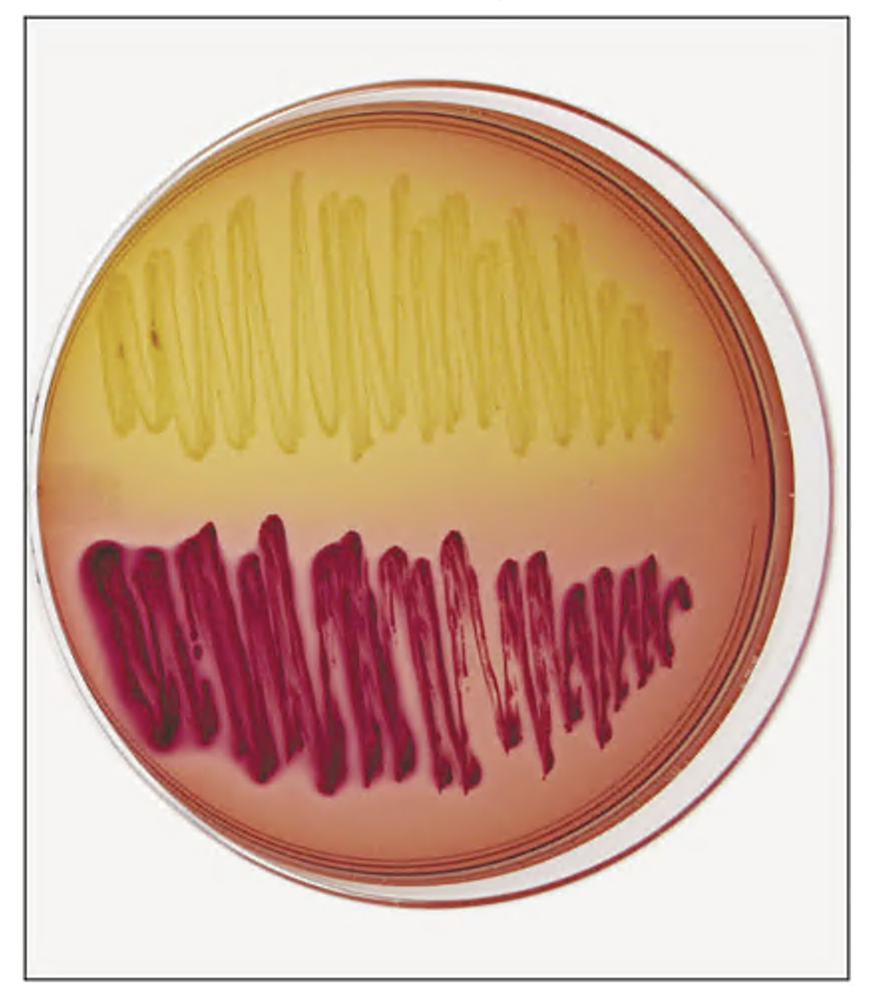
MacConkey agar plate showing two bacteria: one pale yellow (Gram-negative, non-lactose fermenter) and one pink-red (Gram-negative, lactose fermenter).

Back
BackProblem 1
Label the following drawing using these words: adhesin, exotoxin, H antigens, hemolysin, iron-binding protein, K antigens, outer membrane (with common antigen, lipid A, and O antigen), fimbria, plasmid virulence genes, type III secretion system.
Problem 1
The presence of lipid A in the outer membranes of Gram-negative bacteria.
a. Affects the formation of blood clots in the host
b. Causes these bacteria to be oxidase positive
c. Triggers the secretion of a protease enzyme to cleave IgA in mucus
d. Enables enteric bacteria to ferment glucose anaerobically
Problem 1
A physician prescribes fluid replacement to treat a patient with diarrhea. Although tests showed that a pathogenic enteric bacterium was the cause of the intestinal distress, an antimicrobial drug was not prescribed; why not?
Problem 1
Match each bacterium with the disease or manifestations it causes.
1. _____ Escherichia coli
2. _____ Klebsiella pneumoniae
3. _____ Proteus mirabilis
4. _____ Salmonella enterica serotype Typhi
5. _____ Shigella flexneri
6. _____ Yersinia pestis
A. Bubonic plague
B. Typhoid fever
C. Gastroenteritis
D. Kidney stones
E. Pus-filled, bloody stools; cramps; fever; and diarrhea
F. Pneumonia
Problem 2
Shown is a MacConkey agar plate. Describe the Gram reaction and lactose fermentation of the two different bacteria shown.
Problem 2
Distinguish among the pathogenicity of coliforms, noncoliforms, and truly pathogenic enteric bacteria.
Problem 2
The only genus of Gram-negative cocci that causes significant disease in humans is
a. Pasteurella
b. Salmonella
c. Klebsiella
d. Neisseria
Problem 3
Which of the following bacterial cells is most likely to be virulent?
a. A cell with fimbriae and LOS
b. A cell with a polysaccharide capsule and lipooligosaccharide
c. A cell with fimbriae, lipooligosaccharide, and a polysaccharide capsule
d. A cell with fimbriae but no capsule
Problem 3
Why do nurses place antimicrobial agents in babies’ eyes at birth?
Problem 4
Which of the following statements is true?
a. PID is a severe type of diarrhea in which infection spreads from the intestines to
the bloodstream.
b. PID can result from Neisseria infection.
c. PID is more common in men than women.
d. Members of the family Enterobacteriaceae usually cause PID.
Problem 4
Statistics show that meningococcal diseases are more frequent in college dormitories and military barracks than in the population at large. Suggest an explanation of this observation.
Problem 5
Why might an alcoholic be susceptible to pulmonary disease?
Problem 5
A coliform bacterium that likely contaminates dairy products is ___________.
a. Bartonella
b. Serratia
c. Enterobacter
d. Proteus
Problem 6
Name six factors that facilitate the production of disease by Bordetella pertussis.
Problem 6
Capsules of pathogenic enteric bacteria are virulence factors because they __________.
a. Capture iron from hemoglobin and store it in the bacteria
b. Release hemolysins that destroy red blood cells
c. Produce fimbriae that enable the bacteria to attach to human cells
d. Protect the bacteria from phagocytosis and from some antibodies
Problem 7
Which of the following bacteria might be responsible for the formation of petechiae in a host?
a. Neisseria meningitidis
b. Escherichia coli O157:H7
c. Klebsiella
d. Proteus mirabilis
Problem 7
Given that pseudomonads are present in almost every moist environment, why do they cause less disease than other, less prevalent Gram-negative bacteria?
Problem 8
The pathogen Haemophilus influenzae b causes.
a. Meningitis in children
b. Upper respiratory flu
c. Endocarditis
d. Genital chancroid
Problem 8
Although an effective vaccine is available to eradicate pertussis in the United States, why has the number of reported cases increased since the 1970s?
Problem 9
What two illnesses can be caused by Legionella pneumophila?
Problem 9
Which of the following diseases is typically mild?
a. Brazilian purpuric fever
b. Bartonellosis
c. Pediatric meningitis
d. Cat scratch disease
Problem 10
What attribute of Coxiella burnetii enables it to survive desiccation and heat for an extended time?
Problem 10
Which bacterium causes infections in many burn victims?
a. Moraxella catarrhalis
b. Pseudomonas aeruginosa
c. Escherichia coli
d. Bartonella bacilliformis
Problem 11
What virulence factors allow Gram-negative anaerobes to cause disease?
Problem 11
Which of the following statements is true of Q fever?
a. For many years its cause was questionable.
b. It was first described in 1976 during an outbreak in Quincy, Massachusetts.
c. Researchers found it could be effectively treated with quinine.
d. The sharp spikes of fever on patients' temperature charts resemble porcupine quills.
Problem 12
Which of the following is a bile-tolerant anaerobe?
a. Bacteroides
b. Escherichia
c. Shigella
d. Prevotella
Problem 12
What single biochemical test result distinguishes gamma-proteobacteria in the family Enterobacteriaceae from gammaproteobacteria in the family Pasteurellaceae?
Problem 13
Describe transovarian transmission of a pathogen.